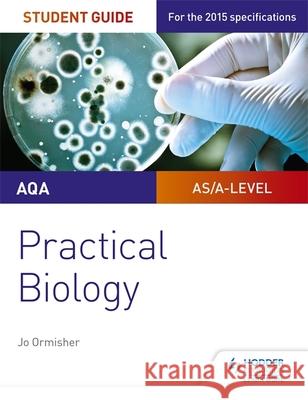
AQA A-level Biology Student Guide: Practical Biology Jo Ormisher 9781471885587

topmenu
Wyniki wyszukiwania:
wyszukanych pozycji: 5
 |
AQA A-level Biology Workbook 2
ISBN: 9781510483170 / Angielski / Miękka / 2020 / 104 str. Termin realizacji zamówienia: ok. 30 dni roboczych. |
cena:
49,48 |
|
AQA A-level Biology Student Guide: Practical Biology
ISBN: 9781471885587 / Angielski / Miękka / 2017 / 104 str. Termin realizacji zamówienia: ok. 30 dni roboczych. Ensure your students get to grips with the core practicals and develop the skills needed to succeed with an in-depth assessment-driven approach that builds and reinforces understanding; clear summaries of practical work with sample questions and answers help to improve exam technique in order to achieve higher grades.
Ensure your students get to grips with the core practicals and develop the skills needed to succeed with an in-depth assessment-driven approach that b...
|
cena:
59,89 |
 |
Practice makes permanent: 300+ questions for AQA GCSE Biology
ISBN: 9781510476424 / Angielski Termin realizacji zamówienia: ok. 30 dni roboczych. Practise and prepare for AQA A-level Biology with hundreds of topic-based questions and one complete set of exam practice papers designed to strengthen knowledge and prepare students for the exams. This extensive practice book raises students' performance by providing 'shed loads of practice', following the 'SLOP' learning approach that's recommended by teachers. - Consolidate knowledge and understanding with practice questions for every topic and type of question, including multiple-choice, multi-step calculations and extended response questions. - Develop the mathematical, literacy...
Practise and prepare for AQA A-level Biology with hundreds of topic-based questions and one complete set of exam practice papers designed to strengthe...
|
cena:
54,68 |
 |
Aiming for an A in A-level Biology
ISBN: 9781510424098 / Angielski / Miękka / 2018 / 96 str. Termin realizacji zamówienia: ok. 30 dni roboczych. Exam Board: AQA, CCEA, Edexcel, OCR, WJEC/Eduqas Level: A-level Subject: Biology First teaching: September 2015 First exams: Summer 2017 Master the skills you need to set yourself apart and hit the highest grades; this year-round course companion develops the higher-order thinking skills that top-achieving students possess, providing step-by-step guidance, examples and tips for getting an A grade. Written by experienced author and teacher Jo Ormisher, Aiming for an A in A-level Biology: - Helps you develop the 'A grade skills' of analysis, evaluation, creation and application...
Exam Board: AQA, CCEA, Edexcel, OCR, WJEC/Eduqas Level: A-level Subject: Biology First teaching: September 2015 First exams: Summer 2017 Ma...
|
cena:
65,10 |
 |
Practice makes permanent: 600+ questions for AQA GCSE Combined Science Trilogy
ISBN: 9781510476448 Termin realizacji zamówienia: ok. 30 dni roboczych. Practise and prepare for AQA GCSE Combined Science with hundreds of topic-based questions and one complete set of exam practice papers designed to strengthen knowledge and prepare students for the exams. This extensive practice book raises students' performance by providing 'shed loads of practice', following the 'SLOP' learning approach that's recommended by teachers. - Consolidate knowledge and understanding with practice questions for every topic and type of question, including multiple-choice, multi-step calculations and extended response questions. - Develop the mathematical,...
Practise and prepare for AQA GCSE Combined Science with hundreds of topic-based questions and one complete set of exam practice papers designed to str...
|
cena:
80,72 |










